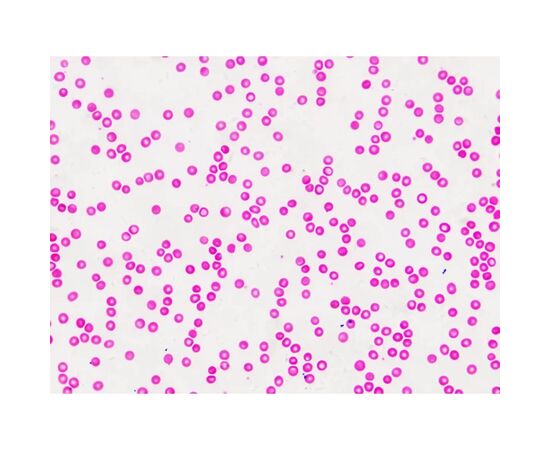

Набор микропрепаратов Bresser Histology 30 шт (5985000) (931505)
Войдите в учётную запись, чтобы мы могли сообщить вам об ответе
- Все о товаре
- Описание
- Особенности
- Отзывы
Описание Набор микропрепаратов Bresser Histology 30 шт (5985000) (931505)
набор микропрепаратов, Количество образцов - 30 шт, 15 х 11 х 3.5 см
Характеристики Набор микропрепаратов Bresser Histology 30 шт (5985000) (931505)
Количество образцов
30 шт
Бренд
Bresser
Артикул
931505
Модель
Histology 30 шт (5985000)
Состав набора
- набор микропрепаратов
Габариты упаковки
- 15 х 11 х 3.5 см
Страна производства
Китай
Гарантия, мес
1
Важное примечание
Производитель может менять свойства, характеристики, внешний вид и комплектацию товаров без предварительного уведомления
Отзывы о Набор микропрепаратов Bresser Histology 30 шт (5985000) (931505) от реальных покупателей
Отзывы не найдены